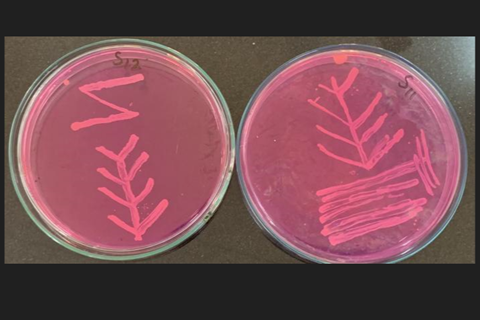
mast

Raw cow and sheep milk is frequently contaminated with antibiotic-resistant bacteria that could pose a threat to human and animal health, reports a new study led by Tahir Usman of Abdul Wali Khan University Mardan, Pakistan, published November 12, 2025 in the open-access journal PLOS One.
In Pakistan, over 95% of milk is consumed in its raw form, which has not been pasteurized to kill off harmful bacteria. Milk can become contaminated by bacteria through improper handing or from infections in the teat, called subclinical mastitis.
READ MORE: Safety and nutritional claims for raw milk
READ MORE: E. coli strain in Egyptian dairy products also found in Japan school outbreak
The overuse of antibiotics to treat subclinical sumastitis has led to the emergence of multidrug-resistant bacterial strains, which could then be transmitted to humans through raw milk.
Mastitis-causing bacteria
In the new study, researchers investigated the risk posed by Staphylococcus epidermidis, a subclinical mastitis-causing bacteria that often does not lead to visible symptoms in the cow, but results in contaminated, lower-quality milk. They collected 310 milk samples, about half from cattle and half from ewes, and tested them for subclinical mastitis. They also isolated strains of Staphylococcus epidermidis from the milk samples and screened them for antibiotic resistance.
About one quarter of the samples showed evidence of subclinical mastitis and almost 13% (1 in 8) were contaminated with Staphylococcus epidermidis. Strikingly, 95% of Staphylococcus epidermidis bacteria isolated from the milk were resistant to penicillin and erythromycin, and half were resistant to three or more antibiotics.
In humans, Staphylococcus epidermidis is a common, generally harmless inhabitant of the skin, but the researchers point out that multi-drug resistant Staphylococcus epidermis bacteria in raw milk could spread antimicrobial resistance to more harmful pathogens, like Staphylococcus aureus, the MRSA pathogen.
High rates of antibiotic resistance
The study’s findings underscore the high rates of subclinical mastitis in cattle and ewes, and indicate that Staphylococcus epidermidis might be an important pathogen impacting both animal health and food safety. The high rates of antibiotic resistance observed in the samples also emphasize the urgent need for improved antibiotic stewardship in agriculture to prevent the rise of multi-drug resistant strains.
The authors add: “The presence of multidrug-resistant Staphylococcus epidermidis in raw milk highlights how on-farm antibiotic use directly shapes public health risks. These findings emphasize the urgent need for responsible antibiotic use and improved hygiene practices in the dairy sector to reduce the risk of antimicrobial resistance transmission through the food chain.”
No comments yet